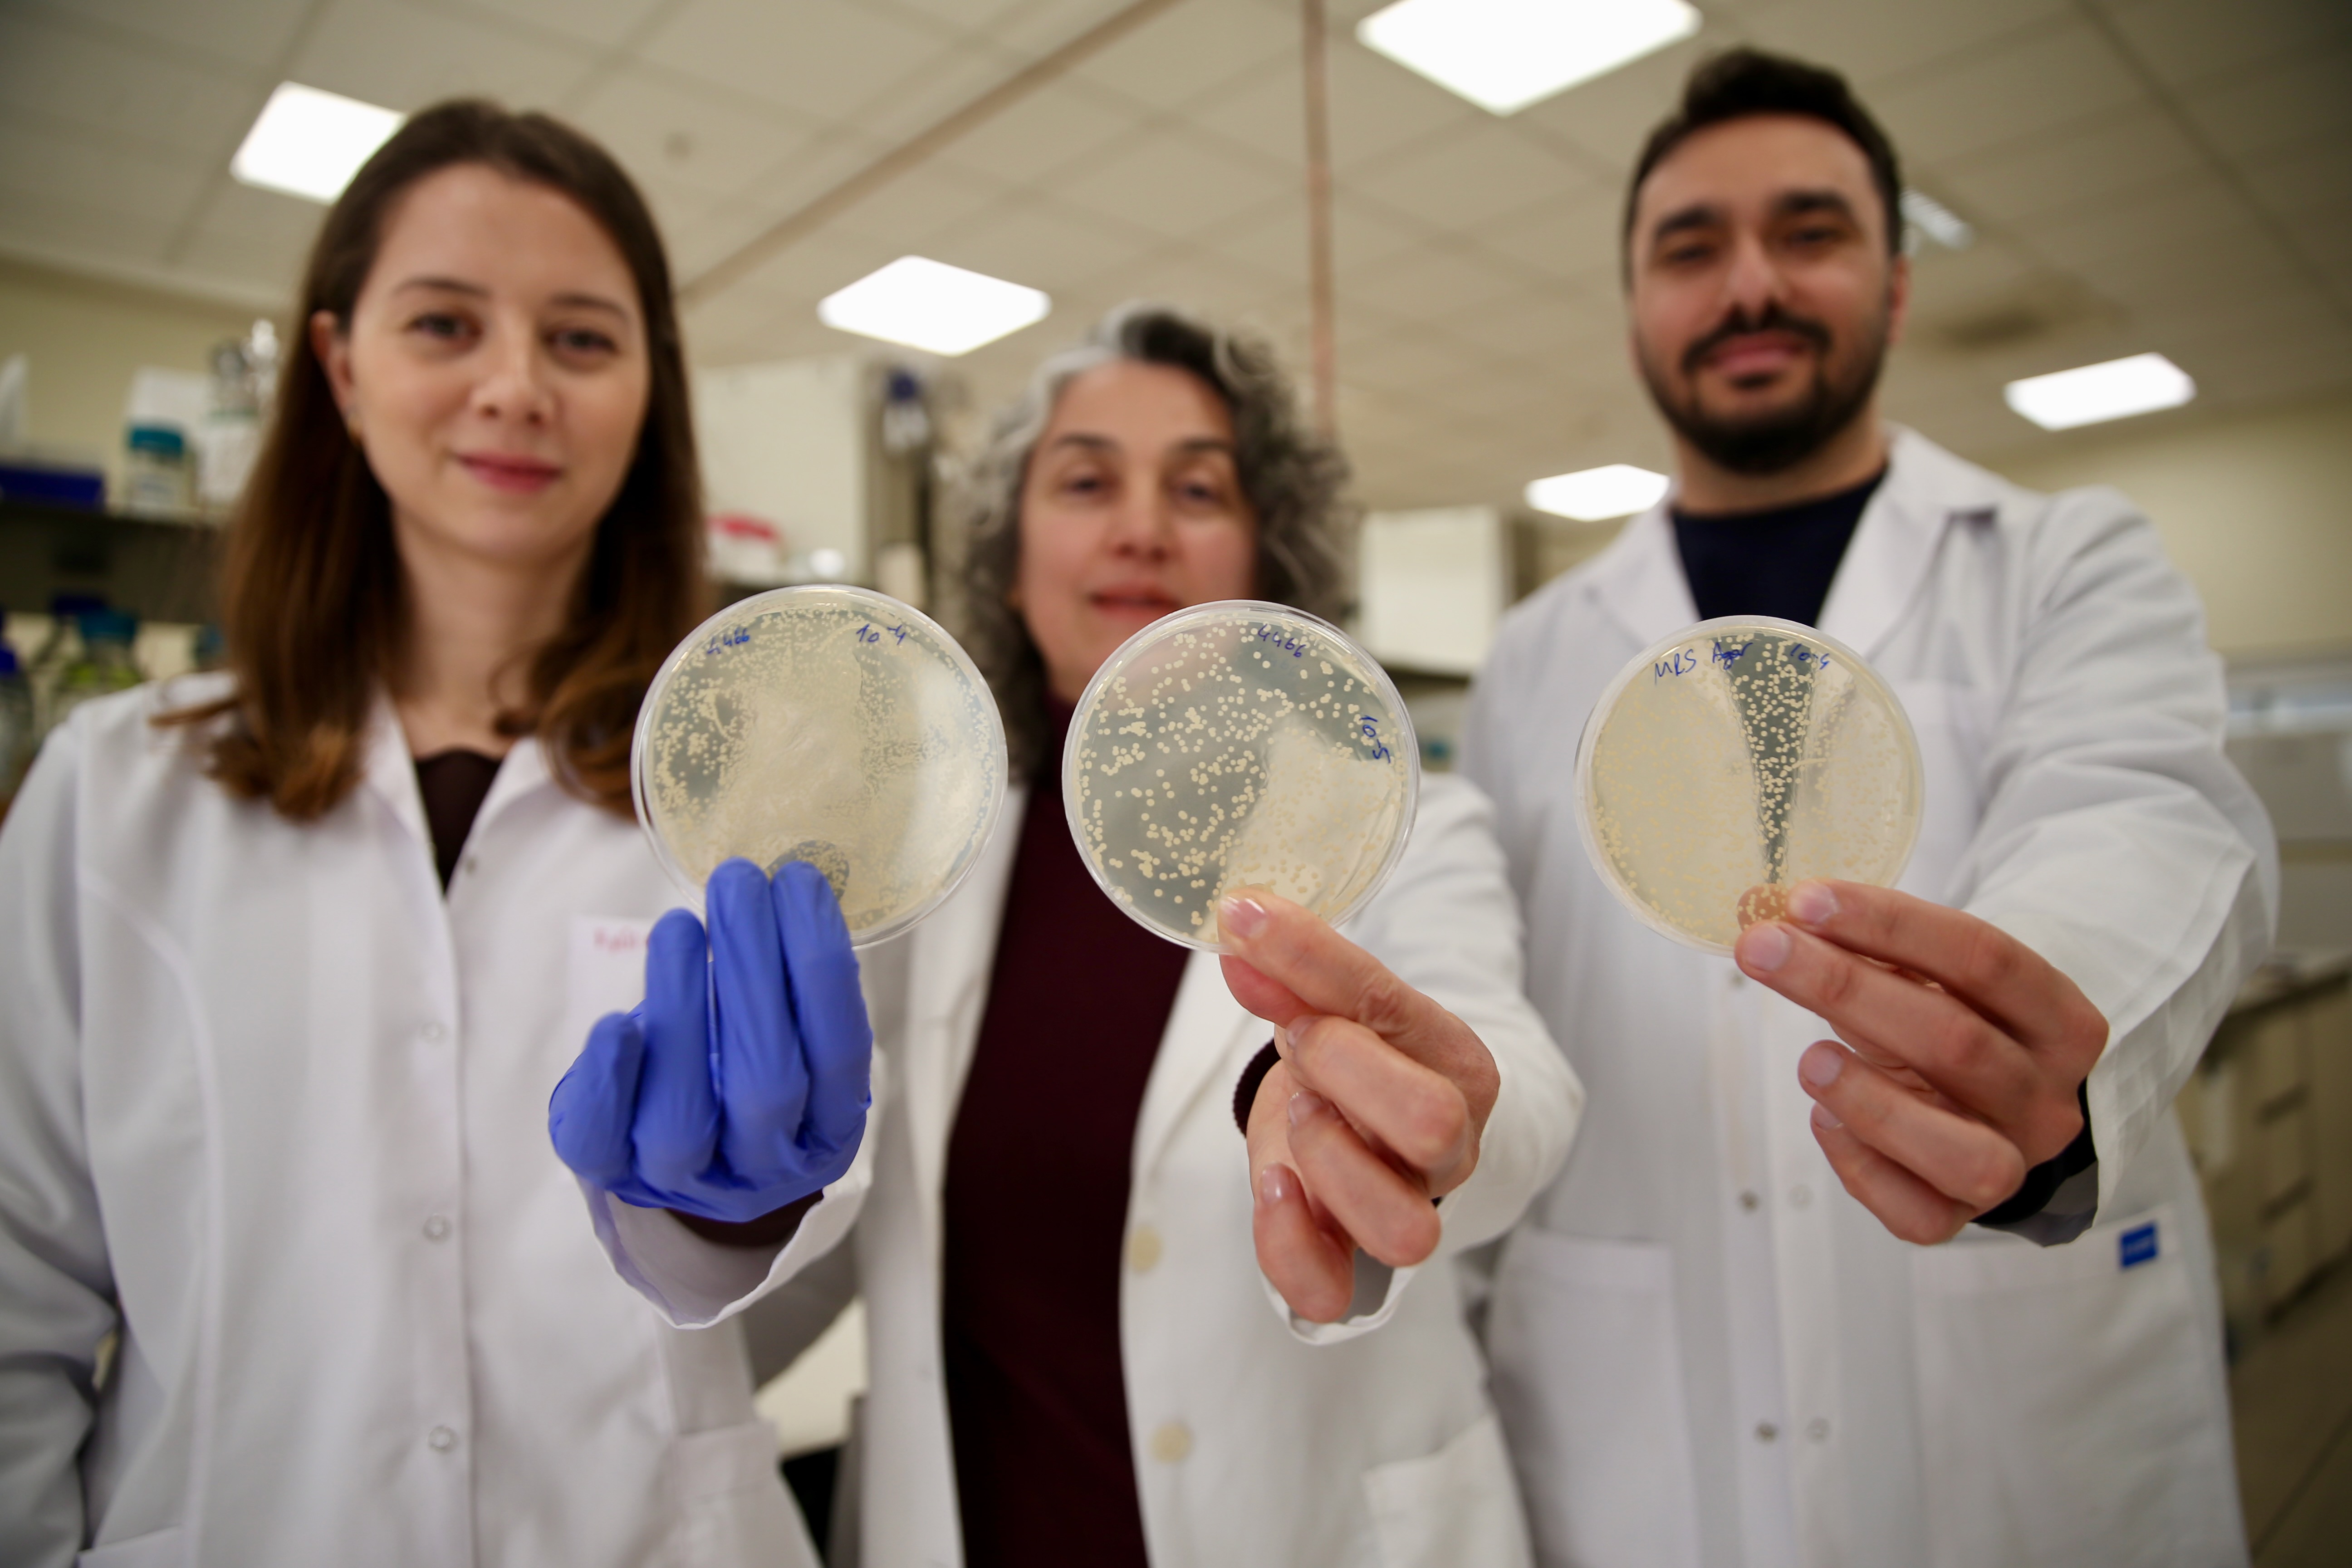

Ekolojik dengeye zarar vermeden sivrisinekle mücadele çalışmaları kapsamında "Biyoinsektisit" adlı proje hazırlayan Gedik, bakterinin ürettiği toksin proteinlerin toz halinde kullanılarak sivrisinek popülasyonunun kontrol altına alınmasını amaçlayan çalışmasıyla "TÜBİTAK-3501 Kariyer Geliştirme Programı"ndan destek aldı. Gedik, havuz, kanal, göl ve bataklık kenarları gibi durgun sulardaki larvaların ergen sivrisinek olmadan çoğalmasını engellemeyi amaçlayan ve bir ilaç firmasıyla lisans anlaşması yapılan ürününü, iki yıl içerisinde piyasaya sürerek ticarileştirmeyi hedefliyor. Prof. Dr. Gedik, geliştirdikleri teknolojinin sivrisinekle mücadelede kullanılacak çevre dostu biyolojik ajanlardan oluşan sistem olduğunu anlattı. Sivrisinekle mücadelede kimyasallarla yapılan mücadelenin tüm ekolojik dengeyi bozduğuna dikkati çeken Gedik, "Normalde hedef odaklı çevre dostu biyolojik ajanların bu mücadelede kullanılması çok önemli. Bacillus bakterileri, sivrisinek larvalarını öldüren proteinler üretiyor. Bu proteinler sadece sivrisinek larvalarını hedef alıyor ve onları öldürüyor. Diğer canlılara zarar vermeyen bu bakteriler, kimyasallara da alternatif olduğu için çok kıymetli." diye konuştu.

"ÇEVREYE ZARAR VERMEDEN YAPILABİLECEK"
Patentlerini aldıkları ürünle ilgilenen bir sanayicinin firmasıyla da lisanslama anlaşması yaptıklarını aktaran Gedik, bakterinin içindeki toksin proteinleri genetik mühendisliği tekniğiyle artırdıklarını, bu sayede kısa sürede sivrisinek üzerinde etkisini gösterdiğini kaydetti. Gedik, toksin proteinlerin sivrisinekler üzerindeki etkisine ilişkin şu bilgileri verdi, "Kristal toksin proteinleri, bakterinin ürettiği proteinler. Bakterileri büyük ölçekli büyütüyoruz, sıvı kısmından ayırdıktan sonra içindeki proteinleri toz haline getiriyoruz. Tozu sulak alanlara uyguluyoruz. Sivrisinekler gelip yumurtalarını bırakıyor. Yumurtadan çıkan larvalar bu kristal proteinleri yediği zaman ölüyor. Dolayısıyla ergen sivrisinek olmuyor. Bu şekilde sivrisinekleri hedef alan doğal bir ürün oluyor. Durgun sularda kullanılabilir. Dere, havuz, kanal, göl ve bataklık kenarları olabilir. Sivrisineklerin yumurtlamayı tercih ettikleri her bölgeye uygulanabilir bu ürün toz halinde." İlacın kısa sürede sivrisinekleri öldürdüğüne dikkati çeken Gedik, "Genetik mühendisliği teknikleri kullanarak üretilen proteinin miktarını artırabildik. Dolayısıyla kısa zamanda çok daha fazla ürün üretebilen bir bakterimiz olmuş oldu." dedi. Gedik, Bilecik bölgesindeki bir fabrikada üretiminin gerçekleşebileceğini, sistem hazırlandığında iki sene içerisinde üretime geçilebileceğini sözlerine ekledi.